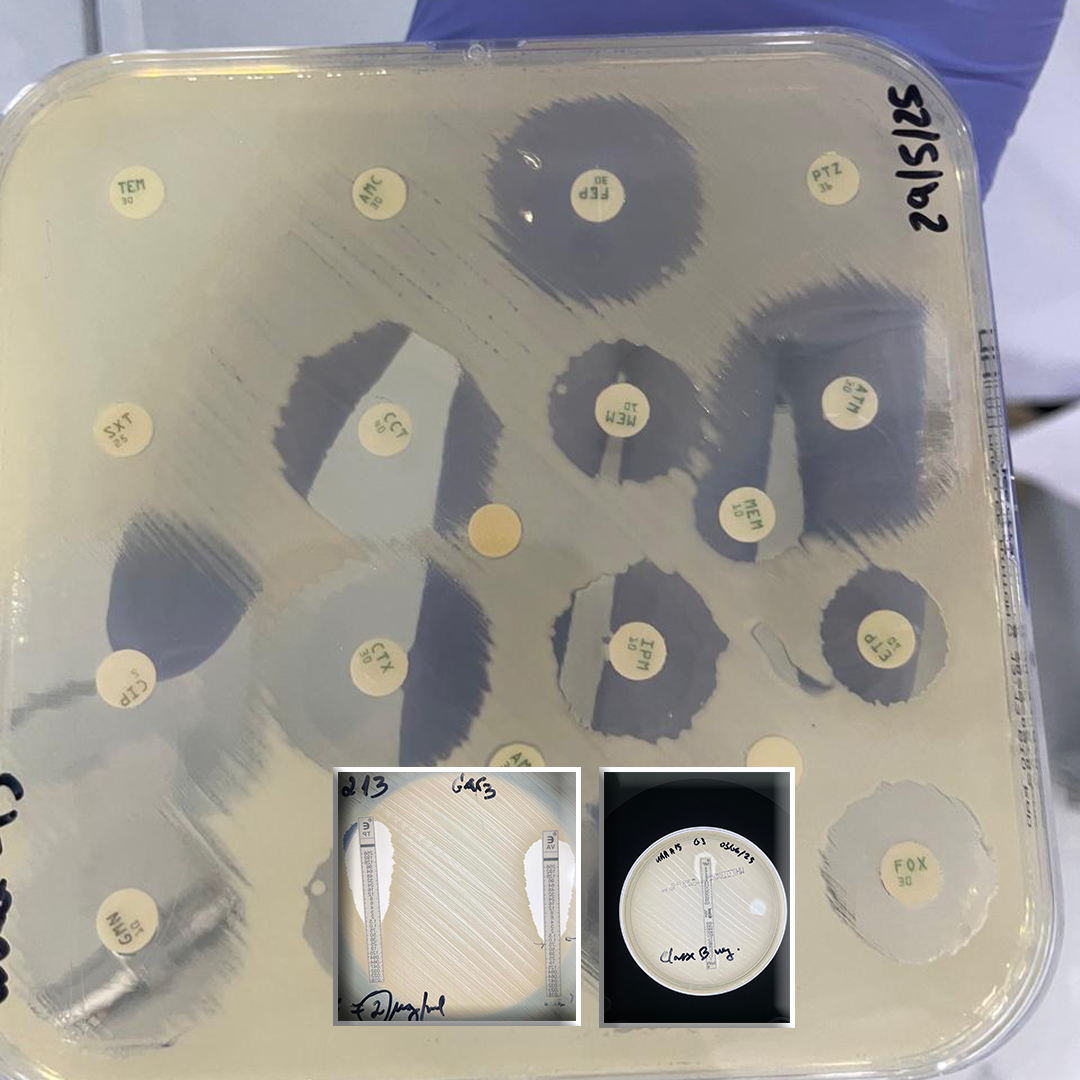
1080x1080

ÚLTIMO BOLETIM
Doenças Negligenciadas
A 6ª edição do Boletim de Saúde Pública do INSP destaca o compromisso de Cabo Verde com a produção e difusão de evidência científica para fortalecer a vigilância epidemiológica, a capacidade laboratorial e a resposta aos principais desafios sanitários do país.
O principal artigo apresenta a Carta Microbiológica de Santiago 2024, que revela o perfil de suscetibilidade dos principais patógenos clínicos e evidencia tendências de resistência antimicrobiana, reforçando a necessidade de estratégias de uso racional de antibióticos.
A edição inclui também uma análise espacial e de serie temporal da tuberculose pulmonar referente ao período 2009–2023, identificando áreas prioritárias para intervenções com base em georreferenciação.
No âmbito das doenças tropicais negligenciadas, são descritos dois casos: um caso importado de esquistossomose urinária no Tarrafal de Santiago e um caso de Síndrome de Guillain-Barré em São Filipe, associado a infeções virais como o dengue. Ambos reforçam a importância da vigilância ativa e integrada.
No conjunto, a edição evidencia o avanço do sistema nacional de vigilância, a qualidade técnica dos estudos e a relevância da investigação aplicada para apoiar a tomada de decisão em saúde pública em Cabo Verde.